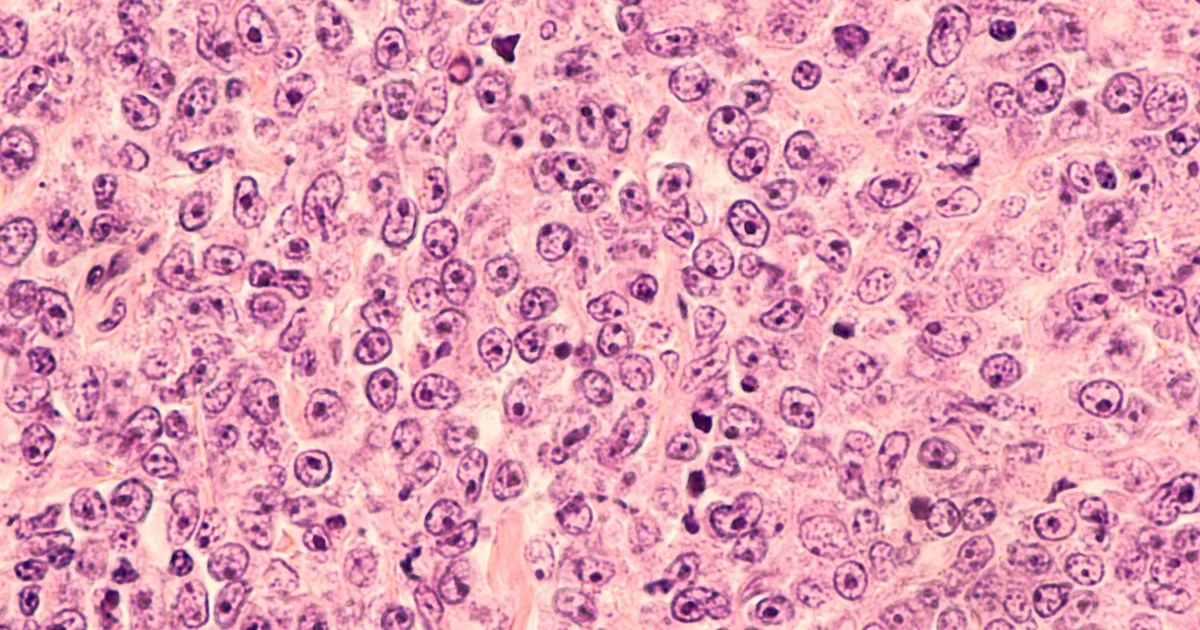

Diagnostyka chłoniaka wymaga przeprowadzenia szeregu specjalistycznych badań krwi, które pomagają w wykryciu choroby oraz ocenie jej zaawansowania. Choć same badania krwi nie są wystarczające do postawienia ostatecznej diagnozy, dostarczają cennych informacji o stanie zdrowia pacjenta. Wśród najważniejszych testów znajdują się morfologia krwi oraz badania biochemiczne, które mogą ujawnić nieprawidłowości w organizmie.
W artykule przedstawimy kluczowe badania krwi stosowane w diagnostyce chłoniaka oraz znaczenie markerów nowotworowych, które pomagają w ocenie aktywności choroby. Zrozumienie tych testów jest istotne dla pacjentów oraz ich bliskich, aby mogli lepiej orientować się w procesie diagnostycznym i leczeniu.
Kluczowe informacje:
- Podstawowym badaniem jest morfologia krwi, która wykrywa nieprawidłowości, takie jak niedokrwistość czy zmiany w liczbie białych krwinek.
- Badania biochemiczne oceniają funkcje wątroby i nerek, co jest ważne przed rozpoczęciem leczenia.
- Markery nowotworowe, takie jak dehydrogenaza mleczanowa (LDH) i beta-2-mikroglobulina, pomagają monitorować postęp choroby.
- Biopsja węzła chłonnego jest kluczowa dla potwierdzenia diagnozy chłoniaka.
- Dodatkowe badania, takie jak testy na wirusy i badania obrazowe, są również zalecane w diagnostyce chłoniaka.
Jakie badania krwi są kluczowe w diagnostyce chłoniaka?
W diagnostyce chłoniaka kluczowe są badania krwi, które pomagają w identyfikacji choroby oraz ocenie jej zaawansowania. Choć same testy krwi nie są wystarczające do postawienia ostatecznej diagnozy, dostarczają cennych informacji o stanie zdrowia pacjenta. Regularne wykonywanie tych badań, na przykład raz w roku, jest częścią profilaktyki zdrowotnej, która może wykryć nieprawidłowości na wczesnym etapie.
Wśród najważniejszych badań znajdują się morfologia krwi oraz badania biochemiczne. Te testy mogą ujawnić zmiany w liczbie krwinek czerwonych, białych oraz płytek krwi, a także ocenić funkcję narządów wewnętrznych. Dzięki tym informacjom lekarze mogą lepiej zrozumieć, jak organizm pacjenta reaguje na chorobę i jakie dalsze kroki diagnostyczne są konieczne.
Morfologia krwi - co mówi o stanie zdrowia pacjenta?
Morfologia krwi, znana również jako kompleksowe badanie krwi, jest podstawowym testem diagnostycznym, który ocenia różne składniki krwi. W szczególności, może wykryć niedokrwistość, co wskazuje na zmniejszoną liczbę krwinek czerwonych, oraz zmiany w liczbie i wyglądzie białych krwinek, w tym limfocytów. Te nieprawidłowości mogą sugerować obecność chłoniaka lub innych schorzeń hematologicznych.
- Wyniki morfologii krwi mogą ujawnić niedobory w organizmie, które są istotne w kontekście diagnostyki chłoniaka.
- Zmiany w liczbie płytek krwi mogą wskazywać na problemy z krzepliwością, co jest ważne dla dalszego leczenia pacjenta.
- Regularne monitorowanie wyników morfologii krwi pomaga w wczesnym wykrywaniu potencjalnych problemów zdrowotnych.
Badania biochemiczne - ocena funkcji narządów przed leczeniem
Badania biochemiczne odgrywają kluczową rolę w diagnostyce chłoniaka, ponieważ pozwalają na ocenę funkcji narządów przed rozpoczęciem terapii. W szczególności, testy te obejmują próbki krwi, które analizują funkcjonowanie wątroby i nerek. Na przykład, poziom kreatyniny i mocznika może wskazywać na to, jak dobrze działają nerki. Z kolei próby wątrobowe, takie jak aminotransferazy, pomagają ocenić stan wątroby, co jest istotne w kontekście leczenia.
Oprócz tych podstawowych testów, badania biochemiczne mogą również obejmować pomiar poziomu albuminy oraz kwasu moczowego. Niski poziom albuminy może sugerować zaawansowaną chorobę, a wysoki poziom kwasu moczowego może wskazywać na problemy z metabolizmem. Dzięki tym informacjom lekarze mogą dostosować plan leczenia oraz monitorować ewentualne powikłania związane z terapią chłoniaka.
Jakie markery nowotworowe są istotne w diagnozie chłoniaka?
W diagnostyce chłoniaka istotne są różne markery nowotworowe, które pomagają w ocenie zaawansowania choroby oraz odpowiedzi na leczenie. Markery te są substancjami, które mogą być wykrywane we krwi lub tkankach i często są produkowane w większych ilościach przez komórki nowotworowe. Na przykład, dehydrogenaza mleczanowa (LDH) jest jednym z kluczowych markerów, którego podwyższony poziom może wskazywać na aktywność choroby oraz jej zaawansowanie.
Kolejnym ważnym markerem jest beta-2-mikroglobulina, która jest używana do oceny postępu choroby i monitorowania reakcji na leczenie. Wysokie stężenie tego markera może sugerować, że chłoniak jest w bardziej zaawansowanym stadium. Oprócz tych dwóch markerów, lekarze mogą również oceniać poziom immunoglobulin, które pomagają w ocenie stanu układu odpornościowego pacjenta. Analiza tych markerów dostarcza cennych informacji, które mogą wpłynąć na decyzje terapeutyczne.
Dehydrogenaza mleczanowa (LDH) - znaczenie w ocenie choroby
Dehydrogenaza mleczanowa (LDH) jest enzymem, którego poziom we krwi ma istotne znaczenie w ocenie postępu chłoniaka. Wzrost stężenia LDH może wskazywać na zaawansowany etap choroby, ponieważ enzym ten jest uwalniany do krwi w wyniku uszkodzenia tkanek, w tym tkanek nowotworowych. Wysokie wartości LDH są często związane z większą masą nowotworową oraz szybszym przebiegiem choroby, co czyni ten marker kluczowym w monitorowaniu stanu pacjenta.
W praktyce klinicznej, pomiar poziomu LDH jest stosowany jako część rutynowej diagnostyki i monitorowania pacjentów z chłoniakiem. Obserwacja zmian w stężeniu LDH może pomóc lekarzom ocenić skuteczność terapii oraz zidentyfikować ewentualne nawroty choroby. Warto jednak pamiętać, że podwyższone stężenie LDH może być również wynikiem innych schorzeń, dlatego zawsze należy interpretować wyniki w kontekście całego obrazu klinicznego pacjenta.
Beta-2-mikroglobulina - jak wpływa na monitorowanie leczenia?
Beta-2-mikroglobulina to inny istotny marker nowotworowy, który odgrywa kluczową rolę w monitorowaniu leczenia chłoniaka. Jego poziom we krwi jest często używany do oceny zaawansowania choroby oraz odpowiedzi na terapię. Wysokie stężenie beta-2-mikroglobuliny może sugerować, że chłoniak jest w bardziej zaawansowanym stadium, co może wpłynąć na decyzje terapeutyczne.
W trakcie leczenia, regularne pomiary beta-2-mikroglobuliny pozwalają na ocenę skuteczności terapii. Obniżenie poziomu tego markera wskazuje na pozytywną odpowiedź na leczenie, podczas gdy jego wzrost może sugerować nawroty choroby lub konieczność zmiany strategii terapeutycznej. Dlatego beta-2-mikroglobulina jest cennym narzędziem w zarządzaniu pacjentami z chłoniakiem i dostarczaniem lekarzom istotnych informacji o postępach w leczeniu.
Czytaj więcej: Na czym polega badanie histopatologiczne i jak ratuje życie pacjentów
Dlaczego biopsja jest niezbędna w potwierdzeniu diagnozy?
Biopsja jest kluczowym krokiem w potwierdzeniu diagnozy chłoniaka, ponieważ pozwala na uzyskanie próbki tkanki, która może być dokładnie zbadana pod kątem obecności komórek nowotworowych. Choć badania krwi dostarczają cennych informacji, to jednak ostateczna diagnoza wymaga analizy histopatologicznej. Biopsja umożliwia lekarzom zrozumienie charakterystyki nowotworu, co jest istotne dla ustalenia odpowiedniego planu leczenia. W zależności od lokalizacji chłoniaka, mogą być zastosowane różne techniki biopsji, co również wpływa na dalsze postępowanie.
Wyróżniamy kilka typów biopsji, w tym biopsję węzła chłonnego, biopsję aspiracyjną cienkoigłową oraz biopsję chirurgiczną. Każda z tych metod ma swoje wskazania i zastosowanie w diagnostyce chłoniaka. Biopsja węzła chłonnego jest najczęściej wykonywaną procedurą, która pozwala na dokładne zbadanie struktury węzła oraz ocenę ewentualnych przerzutów nowotworowych. Dzięki biopsji lekarze mogą nie tylko potwierdzić diagnozę, ale także ocenić stopień zaawansowania choroby, co jest kluczowe dla skutecznego leczenia.
Proces biopsji węzła chłonnego - krok po kroku
Proces biopsji węzła chłonnego zazwyczaj rozpoczyna się od przygotowania pacjenta, który powinien być poinformowany o przebiegu zabiegu oraz jego celu. Następnie lekarz wykonuje znieczulenie miejscowe, aby zminimalizować dyskomfort. Po znieczuleniu, przy użyciu cienkiej igły lub narzędzia chirurgicznego, lekarz pobiera próbkę tkanki z węzła chłonnego. Po zakończeniu zabiegu pacjent jest monitorowany przez krótki czas, aby upewnić się, że nie występują żadne powikłania. Zazwyczaj pacjent może wrócić do normalnych aktywności w ciągu kilku dni, a wyniki biopsji są zazwyczaj dostępne w ciągu kilku dni do tygodnia.
Histopatologiczne badanie tkanki - co można z niego wyczytać?
Histopatologiczne badanie tkanki jest kluczowym elementem w diagnostyce chłoniaka, ponieważ pozwala na dokładną analizę pobranej próbki. Dzięki tej metodzie lekarze mogą ocenić, czy w tkance występują komórki nowotworowe, jak również określić ich typ i stopień złośliwości. Analiza histopatologiczna dostarcza informacji na temat struktury komórek oraz ich organizacji, co może wskazywać na rodzaj chłoniaka oraz jego agresywność. W przypadku chłoniaków, badanie to może również ujawnić cechy, które są istotne dla dalszego leczenia, takie jak obecność markerów immunologicznych.
Wyniki histopatologiczne są niezwykle istotne, ponieważ pomagają w ustaleniu odpowiedniego planu terapeutycznego. Na przykład, różne typy chłoniaków mogą wymagać różnych strategii leczenia, dlatego precyzyjna diagnoza jest kluczowa. Ostatecznie, histopatologiczne badanie tkanki nie tylko potwierdza diagnozę, ale także dostarcza lekarzom informacji, które mogą wpłynąć na rokowanie pacjenta oraz jego dalsze postępowanie medyczne.

Jakie inne badania są zalecane w diagnostyce chłoniaka?
Oprócz standardowych testów krwi i biopsji, w diagnostyce chłoniaka zaleca się również przeprowadzenie dodatkowych badań, takich jak testy wirusowe oraz badania obrazowe. Testy wirusowe, takie jak badania na obecność wirusa Epstein-Barr (EBV) czy wirusowe zapalenie wątroby, mogą być istotne w kontekście niektórych typów chłoniaka. Wykrycie tych wirusów może pomóc w ocenie ryzyka rozwoju nowotworów oraz w dostosowaniu leczenia, zwłaszcza w przypadkach, gdzie wirusy mogą mieć wpływ na przebieg choroby.
Badania obrazowe, takie jak tomografia komputerowa (TK) czy rezonans magnetyczny (RM), są również niezbędne w diagnostyce chłoniaka. Te techniki pozwalają na ocenę zaawansowania choroby, lokalizacji zmian oraz ewentualnych przerzutów. Dzięki tym badaniom lekarze mogą uzyskać pełniejszy obraz stanu pacjenta, co jest kluczowe dla podjęcia decyzji terapeutycznych. W połączeniu z innymi testami, badania obrazowe dostarczają kompleksowych informacji, które są niezbędne do skutecznego leczenia chłoniaka.Nowe technologie w diagnostyce chłoniaka - przyszłość badań
W miarę postępu technologii, diagnostyka chłoniaka staje się coraz bardziej zaawansowana dzięki zastosowaniu innowacyjnych metod, takich jak sekwencjonowanie nowej generacji (NGS) oraz analiza genomowa. Te techniki pozwalają na dokładne badanie materiału genetycznego komórek nowotworowych, co może ujawnić specyficzne mutacje i zmiany genetyczne związane z chłoniakiem. Dzięki temu lekarze mogą lepiej zrozumieć mechanizmy choroby oraz dostosować leczenie do indywidualnych potrzeb pacjenta, co ma kluczowe znaczenie w kontekście personalizacji terapii.
Dodatkowo, rozwój technologii obrazowania, takich jak PET-CT, umożliwia nie tylko dokładną lokalizację zmian nowotworowych, ale także ocenę odpowiedzi na leczenie w czasie rzeczywistym. Takie podejście pozwala na szybsze dostosowanie strategii terapeutycznych, co może znacząco wpłynąć na rokowanie pacjentów. W przyszłości, integracja tych nowoczesnych technologii z klasycznymi metodami diagnostycznymi może przynieść przełomowe zmiany w diagnostyce i leczeniu chłoniaka, poprawiając jakość życia pacjentów oraz zwiększając skuteczność terapii.
